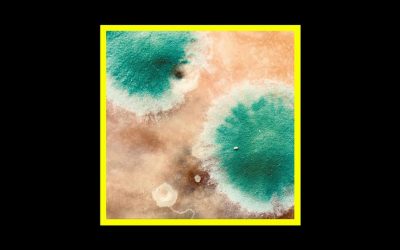
Recensioni Radioaktiv Shackleton & Zimpel – Primal Forms

Dario Capasso / Andrea Laudante – ACR0N
ACR0N, pubblicato il 12 settembre da Liburia Records, è il nuovo album di Andrea Laudante e Dario Capasso.
Joshua Hyslop – Ash and Stone
Pubblicato da Nettwerk, Ash and Stone è il folk pop intimo e vulnerabile del cantautore canadese Joshua Hyslop.
Mammal Hands – Captured Spirits
Ad uno ad uno, i Mammal Hands liberano i loro Captured Spirits, creature meravigliose che sembrano uscite da un altro mondo.
Mana – Asa Nisi Masa
In uscita l’11 settembre 2020 per Hyperdub, Asa Nisi Masa è il nuovo album del torinese Daniele Mana.
Lucrecia Dalt – No era sòlida
In uscita l’11 settembre 2020 per RVNG Intl., No era sòlida è il nuovo album di Lucrecia Dalt, art pop fortemente avanguardistico.
Clinamen – The Tropisms of Spring
Dietro al progetto Clinamen si celano Krzysztof Ostrowski & Jakub Ziołek, The Tropisms of Spring è il loro nuovo album.
Jung Deejay – Java Scripts
Pubblicato il 7 settembre 2020 da Artetetra, Java Scripts è il nuovo lavoro di Randy Riback aka Jung Deejay.
Marta De Pascalis – Sonus Ruinae
All’esordio sulla Morphine Records del libanese Rabih Beaini, la compositrice elettronica Marta de Pascalis pubblica Sonus Ruinae.
H’UM – Zehra
Zehra, pubblicato dalla Deep Voice Records, è il nuovo album di Rosario Di Rosa e Stefano Grasso aka H’UM.
Tricky – Fall to Pieces
A 25 anni dal debutto con Maxinquaye, Tricky pubblica il suo quattordicesimo album, Fall To Pieces, in uscita per False Idols/!K7.
Bruno Bavota – Apartment Songs – Volume Two
Nell’appartamento di Bruno Bavota pare ci fosse un cassetto in più, un po’ nascosto, che conteneva Apartment Songs – Volume Two.
Paul Armfield – Domestic
Il 4 settembre 2020 esce Domestic settimo disco di Paul Armfield che segna un’ulteriore fase per la carriera dell’artista.
Grand River – Blink A Few Times To Clear Your Eyes
Grand River esordisce su Editions Mego con il suo secondo album Blink A Few Times To Clear Your Eyes.
Paolo Ielasi – Why Are You Talking So Loud?
Why Are You Talking So Loud? è il nuovo album di Paolo Ielasi pubblicato il 4 settembre 2020 per la polacca Sublime Retreat.
Galya Bisengalieva – Aralkum
Aralkum, debutto da solista della violinista Galya Bisengalieva, ci spiega cosa ci fa un cammello all’ombra di un peschereccio.
Last Quokka – Unconscious Drivers
Raw punk dall’Australia con i Last Quokka. Unconscious Drivers è il nuovo album pubblicato da Stock Records.
AkA and Cat – Résonances Hyménoptiques
Dall’incontro tra forme d’arte differenti prende vita Résonances Hyménoptiques, un’opera elettro-figurativa firmata da AkA e Cat.
Karin Johansson / Lisen Rylander Löve – Arter
Pubblicato da Havtorn Records, Arter di Karin Johansson e Lisen Rylander Löve si muove tra jazz, improvvisazione e avanguardia.
Gianluca Favaron | Anacleto Vitolo – Overgrowth
Continua il sodalizio artistico tra Gianluca Favaron e Anacleto Vitolo con Overgrowth, il secondo album firmato dal duo.
Attilio Novellino & Our Love Will Destroy The World – The Assault Of Heaven
Attilio Novellino & Our Love Will Destroy The World: The Assault Of Heaven è il nuovo album pubblicato da Opal Tapes.
Old Sea Brigade & Luke Sital-Singh – All the Ways You Sing in the Dark
All The Ways You Sing In The Dark è l’Ep scritto a quattro mani da Old Sea Brigade e Luke Sital-Singh.
Sarah Walk – Another Me
Sarah Walk torna sulle scene, dopo due anni dal suo debutto, con Another Me, una sofisticata rinascita pop attraverso sé stessa.
Peter Broderick – Blackberry
A 5 anni dal suo ultimo lavoro Colours of the Night esce Blackberry per da Erased Tapes, il nuovo album di Peter Broderick.
Jonas David – Goliath
Il 28 agosto 2020 esce Goliath, il disco indie-pop dell’artista internazionale Jonas David per la Haldern Pop Recordings.
Garrett Kato – N. Hemisphere
In principio era il Canada ed è lì che Kato torna per parlarci di ciò che esisteva prima. N. Hemisphere per Nettwerk Music Group.
Ulver – Flowers of Evil
In uscita il 28 agosto 2020 per House of Mitology, Flowers of Evil è il nuovo album degli Ulver.
Enoia – Alien
In uscita per Eklero, Alien di Enoia, è un album ambient che ci trasporta in un profondo abisso di ansia industriale.
Pat Keen – Cells Remain
Pat Keen ha pubblicato il 21 agosto 2020 per Birdwatcher Records il suo nuovo album dal titolo di Cells Remain.
Less Bells – Mourning Jewelry
Mourning Jewelry di Less Bells è la storia di come gli oggetti e le persone siano legati insieme dal filo argenteo della memoria.
The Notwist – Ship
The Notwist: Ship, un nuovo Ep composto da tre canzoni, pubblicato il 21 agosto 2020 da Morr Music.
King Buzzo & Trevor Dunn – Gift of Sacrifice
Gift of Sacrifice è il nuovo album di Roger “Buzz” Osborne, alias King Buzzo, insieme al bassista Trevor Dunn.
Penny Rimbaud – How?
Penny Rimbaud pubblica How? per One Little Independent Records / Audioglobe il 14 agosto 2020.
Son Lux – Tomorrows I
In uscita il 14 agosto 2020 per City Slang, Tomorrows I è il primo capitolo di una trilogia firmata Son Lux.
Fantastic Negrito – Have You Lost Your Mind Yet?
In uscita il 14 agosto 2020, Have You Lost Your Mind Yet? è il nuovo album di Fantastic Negrito.
Berke Can Özcan – Mountains Are Mountains
Con Mountains Are Mountains, pubblicato il 7 agosto 2020, giunge all’esordio solista il batterista, compositore, scrittore e produttore Berke Can Özcan
Jaye Jayle – Prisyn
Prisyn, in uscita il 7 agosto su Sargent House, è ll nuovo lavoro di Jaye Jayle, progetto di Evan Patterson nato dalla collaborazione con il compositore e produttore Ben Chisholm.
Swarvy – Sunny Days Blue
Pubblicato il 7 agosto dalla Black Focus, Sunny Days Blue è l’Ep di debutto del producer di Filadelfia Swarvy.
Glass Animals – Dreamland
In uscita il 7 agosto 2020 per Republic Records, Dreamland è il nuovo album del gruppo inglese Glass Animals.
Steve Von Till – No Wilderness Deep Enough
Steve Von Till pubblica il suo viaggio introspettivo No Wilderness Deep Enough per l’etichetta Neurot Recordings.
Jaga Jazzist – Pyramid
In uscita il 7 agosto 2020 per Brainfeeder, Pyramid è il nuovo album dei Jaga Jazzist, cinque anni dopo Starfire.
Koralle – Fonografie 1
Pubblicato il 31 luglio 2020 da Melting Pot Music, Fonografie 1 è il nuovo Ep del producer bolognese Lorenzo Nada aka Koralle.
Shackleton & Zimpel – Primal Forms
Pubblicato il 31 luglio 2020 via Cosmo Rhythmatic, Primal Forms è l’album collaborativo di Sam Shackleton & Zimpel.
Robin Schlochtermeier – Spectral
In uscita il 31 luglio per Denovali, Spectral è il primo album solista del pluripremiato compositore Robin Schlochtermeier.
Sankt Otten – Lieder für geometrische Stunden
Undicesima release per il duo di Osnabrück Sankt Otten. Lieder für geometrische Stunden, pubblicato il 31 luglio da Denovali.
Alain Johannes – Hum
Pubblicato da Ipecac, Hum è il nuovo disco di Alain Johannes: una via di mezzo tra la salvezza e la caduta.
Dmitry Evgrafov – Surrender
Surrender di Dmitry Evgrafov è più di un semplice album: è musica che diventa storia commovente, esperienza, emozione.
Rival Consoles – Articulation
Successore del valido Persona (2016), Articulation è il settimo album per Rival Consoles, in uscita il 31 luglio 2020 per Erased Tapes.
Abyss X – INNUENDO
Dieci tracce, 35 minuti di musica tra experimental pop e trip hop per l’esordio di Abyss X dal titolo di INNUENDO.
Daniel Blumberg – On&On
In uscita il 31 luglio 2020 per Mute, On&On è il nuovo album di Daniel Blumberg, a due anni di distanza da Minus.
Crush of Souls – Bad Trip
In uscita 31 luglio 2020 per la Third Coming Records, Bad Trip è il nuovo Ep di Crush of Souls, progetto di Charles Rowell.